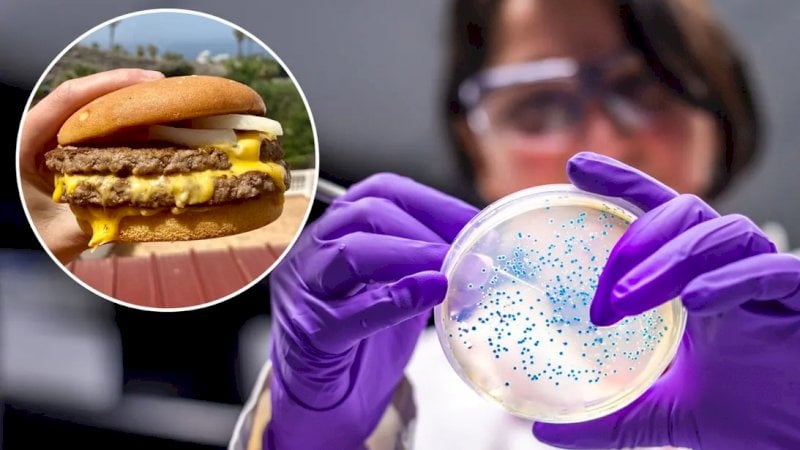

أمريكا تكشف سبب تفشي بكتيريا “إي كولاي” في ماكدونالدز
أعلنت هيئة المراكز الأميركية للسيطرة على الأمراض والوقاية منها انتهاء تفشي بكتيريا “إي كولاي” المرتبطة بشطائر “كوارتر باوند” من “ماكدونالدز”.
وقد حظيت هذه القضية باهتمام لافت على المستويات كافة، سواء شعبياً، أو رسميا، وكذلك على مستوى التناول الإعلامي لأنها ترتبط بقضية خطيرة تتعلق بصحة الإنسان، ولسبب آخر يتمثل في أن ماكدونالدز يمثل أحد الوجوه الناعمة للثقافة الأميركية، فالصورة الذهنية لأميركا لدى الملايين حول العالم ترتبط بـ”ثقافة البرغر”.
“ماك” لديه 42 ألف فرع على المستوى العالمي، منها 14 ألفاً في أميركا، أي أنه أحد أضخم الكيانات في عالم الطعام المطاعم، والدخل العام في عام 2023 بلغ 8.4 مليار دولار على المستوى العالمي.
وأوضحت الهيئة في بيان أن التحقيقات المتعلقة بالواقعة أغلقت، وأن الحصر النهائي حتى الثالث من كانون الأول (ديسمبر) يتمثل في 104 حالات إصابة موزعة في 14 ولاية، تم نقل 34 منها للمستشفى بسبب الإصابة بسلالة تسبب أمراضاً خطيرة، وفقاً لما نشرته عدة مصادر أميركية، وعلى رأسها موقع abcnews.
كان أول بلاغ عن تفشي البكتيريا في 22 تشرين الأول (أكتوبر) الماضي، وتسببت في وفاة شخص واحد، وانتشرت بسبب تناول شطائر تحتوي على بصل طازج مقطع تبين أنه السبب، وفق ما نقلت وكالة رويترز.
توصلت التحقيقات إلى أن مصدر هذا البصل الملوث بالبكتيريا كان شركة موردة تدعى تايلور فارمز تزود به 3 مراكز توزيع تابعة لماكدونالدز.
سحبت تايلور فارمز دفعات من المنتج المتسبب في المشكلة كان قد تم تعبئتها في منشأة بولاية كولورادو، في حين سحبت ماكدونالدز الشطيرة التي يستخدم فيها البصل الطازج من قوائم الطعام بـ 20% من مطاعمها التي يبلغ عددها 14 ألفاً في أميركا.
وبعد مرور فترة على الواقعة، وقبل انتهاء التحقيقات، أعادت ماكدونالدز تقديم البصل الطازج المبشور في مطاعمها بعد التعاقد مع مورد مختلف.



